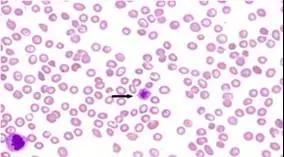

红细胞由骨髓生成后释放到循环血液中,是血液中数量最多的一种血细胞。正常情况下,红细胞从骨髓进入血液循环直至衰老死亡的平均寿命约为120天。每日红细胞约有0.8%(即1/120)死亡,亦有0.8%(约有20亿个)红细胞新生,因此红细胞的生成与破坏之间保持着动态平衡。红十字会建议成年人每隔三四个月献血一次的依据也源于此。

1919年,Ashby开创了差异凝集法红细胞寿命测定技术,使人们对红细胞寿命有了正确的了解。但该方法操作繁杂,仅适合异体试验,难以在临床上应用。

1946年,Shemin提出了稳定核素15N-甘氨酸标记红细胞测定红细胞寿命的方法,实现了自体红细胞寿命测定,但该方法完成一次红细胞寿命测定的时间周期长达四个月,仅适合小样本量的科学研究,国内亦从未开展过。

1950年,Gray和Sterlin提出了放射性核素51Cr标记法,相对于15N-甘氨酸标记法来说操作有了简化,测量周期也缩短到了近一个月。经过不断的修改、简化,1970年,国际血液学标准化委员会(ICSH)确认了51Cr标记法红细胞寿命测定项目的方法学,并在1980年统一了该指标的正常值,促进了其在临床上的应用。

我国于上个世纪60年代初期建立了51Cr标记红细胞测定红细胞寿命的方法,并将其用作诊断溶血的可靠指标。因其方法学的局限性,该法仅在国内少数医院开展过,如中国医学科学院血液病医院、上海瑞金医院和四川大学华西医院等。
51Cr标记属于全龄标记,血液与放射性铬酸钠在体外混合过程中,从新生到衰老的各种龄期红细胞都会受到标记。六价铬离子能够穿透红细胞膜,进入红细胞后被还原成三价铬离子而附在血红蛋白分子的珠蛋白上。红细胞破坏后释放到血液中的三价铬离子不能被重复利用,从而避免了对检测结果的影响。

该法需把体外进行51Cr标记的静脉血回输受试者体内,然后定期采血测定血液中51Cr放射性强度。随着标记红细胞的每天破坏,血液51Cr放射性强度不断下降直至消失,根据放射性下降速率绘制红细胞生存曲线即可计算红细胞寿命。

(引自:《血液病实验诊断》.中国医学院血液病研究所主编.)
因该法耗时较长,临床把血液51Cr放射性强度下降到一半所需时间作为临床诊断指标,即红细胞半寿期(亦称红细胞半生存时间、红细胞的半生存期、红细胞外表半生存期、红细胞的外表半生存时间等),其正常参考值约为25-40天,20天以下为缩短,17天以下为明显缩短。但此值不是红细胞寿命的绝对寿命值,因此51Cr标记法所测得红细胞寿命值需要采用校正系数表进行校正。

51Cr标记法完成一次红细胞寿命测定耗时近一月、操作繁杂、有放射性物质进入人体,且不可随到随测,不可能大规模用于日常临床。目前全国各医院均已终止该项检查(国内唯一生产该检查所需试剂——“铬[51Cr]酸钠注射液”的厂家原子高科股份有限公司已停止该试剂生产),国外也罕有医院使用。

深圳先亚公司研发成熟的CO 呼气试验法红细胞寿命检测技术简单安全、快捷准确,完成一次测量所需时间不到15 min,可随到随测